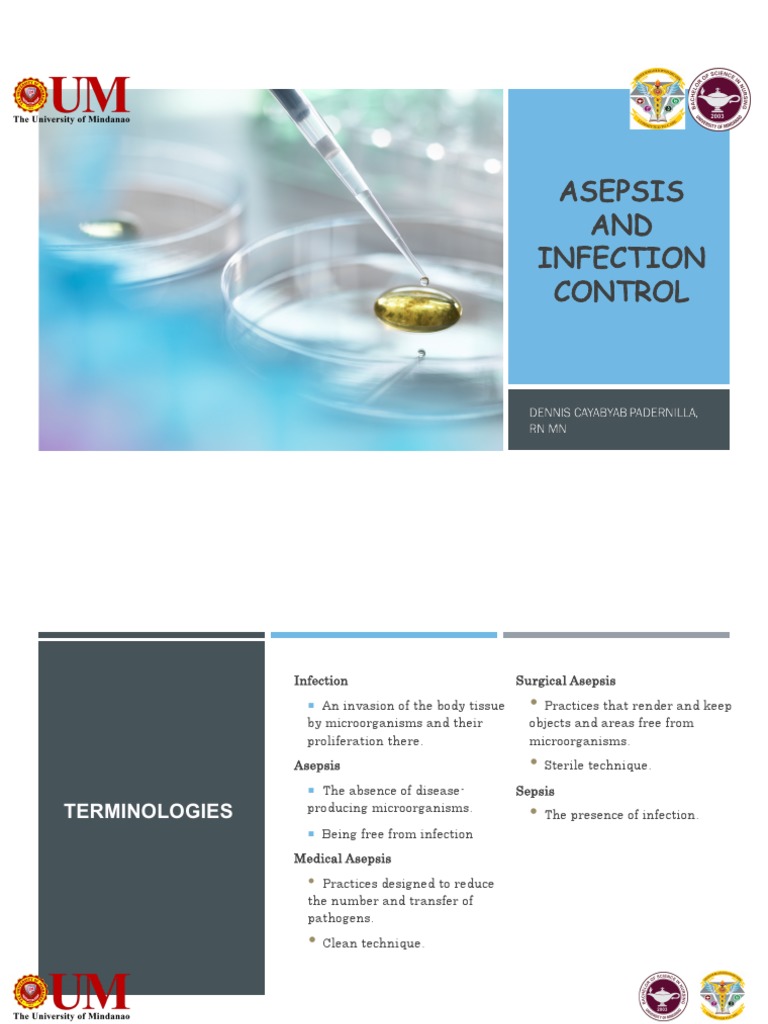
Rle - Asepsis and Infection Control | PDF | Infection | Hand Washing

In addition to the information above, here is a curated collection of images related to Lecture 2 Asepsis And Infection Prevention 215 Lecture 2 Pdf.
- Lecture 2 - Asepsis And Infection Prevention 215 Lecture 2 | PDF
- Understanding Asepsis And Infection Control In Nursing | Course Hero
- Asepsis | PDF | Infection | Hand Washing
- Asepsis And Infection Guided Lecture - Guided Lecture Notes, Chapter 20 ...
- 2021 GS Lesson 2. Asepsis And Antisepsis | PDF | Sterilization ...
Find More About "Lecture 2 Asepsis And Infection Prevention 215 Lecture 2 Pdf"
Explore exclusive offers, detailed information, and related services about lecture 2 asepsis and infection prevention 215 lecture 2 pdf from our trusted partners.
View Special Offers